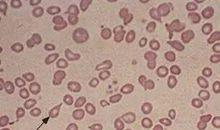
泪滴_900字

作文
女孩的愿望_800字
夜空中令人眼花缭乱的闪耀废料。一天,这是一个流星!一个女孩飞在流星中,闭上眼睛,真诚地拯救了一个愿望。她有许多幻想实现实现愿望的幸福。自童年以来
月考后的我_400字
擦拭这个月后的眼泪,勇敢地抬起头部,牢牢奔跑,无论是成功的,只要我们挣扎,尽量应得。不要说你没有这个,改变你的角度,另一个生命,我们只需要告诉自己不断工作
关于校园的作文:美丽的校园_700字
我走过校园的四季,我回到了春天的花朵和秋季的月份,夏云冬雪,它确实珍贵。进入我们的校园,你会感到强烈的绿色呼吸,一排优秀的松柏柏树,整洁的冬青
关于校园的作文:我爱美丽的校园_600字
我的学校成立于1926年,最初被称为悠久的历史,一个美丽的环境。校园很干净。它具有丰富的文化遗产。在学校是最古老的一条道路 - 人民之路
关于校园的作文:美丽的校园_750字
在年底,我吻了冬天,我拿着日出走出卧室门。我立刻碰到了水分的微风。当我举起时,我发现灌木丛中的教学建筑长期丢失,并且一只小齿架钻孔通过刀片钻孔,似乎柔软
关于校园的作文:美丽的校园_650字
虽然我们每天都要上学,但我们还没有认真读到校园的美丽风景。不久前,张总监张说,她带我们去参观美丽的学校。我们学校的右侧是连续两个列,就像一本开放的书一样
关于校园的作文:美丽的校园_600字
我们的校园不是很大,但布局很精致,简约而美丽。在这里,绿树被遮住,花了覆盖,带有高大直的杨树,有一个榕树在错误的节日中,随着旗杆的旗杆
关于校园的作文:美丽的校园_800字
自然的力量很大,它是神奇的。这不是,春天即将到来,冰融化,一切醒来,更换绿色的新安装,到处都是一种充满活力的场景。在这里鲜花,有一个群集
关于校园的作文:美丽的校园_1500字
校园的春天是如此美丽!绿草,绿色叶子,红色花,明亮的蝴蝶。这就像聚集在一起,形成一个春天美丽的画面。跳投进入学校门,郎朗的读音声伴随着温暖的春风
泪滴_900字
未经许可,不得转载 在阳光灿烂的早晨,阳光闪耀着彩虹的光,在绿草的香水中,一名白发老人举行精致的花朵走向上海南火车站,老人慢慢地走向赛道,凝视着在远处
快乐就好_200字
E.不允许再现Duisen菜单幸福就是生命,我结束了幸福,我会结束生活,幸福是笑容的笑容;幸福是保持良好的态度;幸福是奇迹的根源。在汶川地震中
轰炸过后_450字
E.不允许再现Duisen菜单1937年8月28日,上海火车站,几个日本敌人嗖嗖嗖嗖嗖嗖嗖嗖嗖嗖嗖地下来雨水。经过一系列爆炸后,火车站最多四个,房子倒塌
可怜的战争儿童_350字
E.不允许再现Duisen菜单语言书上的一张照片,深深地触及了我的心:一个小男孩正计划去乡下看疾病,只需进入火车站;爸爸会买到人民售票处的门票。刚买火车票
战争带来的危害_300字
E.不允许再现Duisen菜单1937年3月28日,当日本入侵者轰炸上海火车站时,记者走了现场。 。一个孩子和他的父亲和母亲正准备购买火车票到北京。在这一刻
孤独的孩子_650字
未经许可,不得转载1937年8月28日,天空很黑,太阳覆盖着厚厚的乌云。然而,上海的南火车站仍然很热,而准备上网的人不受限制
一张特别的照片_300字
未经许可,不得转载我正在读一本书在金津!我看着它。突然,一张照片反映在我眼中。这张照片是1937年8月28日,日本入侵者轰炸上海南火车站的真实事物。在照片中
战争的罪恶(课本第三单元习作)_550字
E.不允许再现Duisen菜单这张照片是1937年8月28日,当时日本入侵者轰炸上海火车南火车站,记者占据了真实的现场。有一个孩子在画面哭泣,他是一支小军队
罪恶的战争_600字
E.不允许再现Duisen菜单“繁荣!繁荣!繁荣!”霎时间,声音,呼喊,尖叫是无穷无尽的。超过一小时,这里仍然是大海,和平与一个
肩上的书包_800字
E.不允许再现Duisen菜单我们的肩膀......我经常听到任何声音,“为了减轻负担,让你的孩子一个快乐的童年......”等等,我认为这只是一个口号
腊八节英语作文:the laba Rice Porridge Festival_1200字
Laba Rice Porridge含有糯米(米),红豆,小米,中国高粱,豌豆,干莲子,红豆等其他成分,如干约会,栗子,核桃肉,杏仁